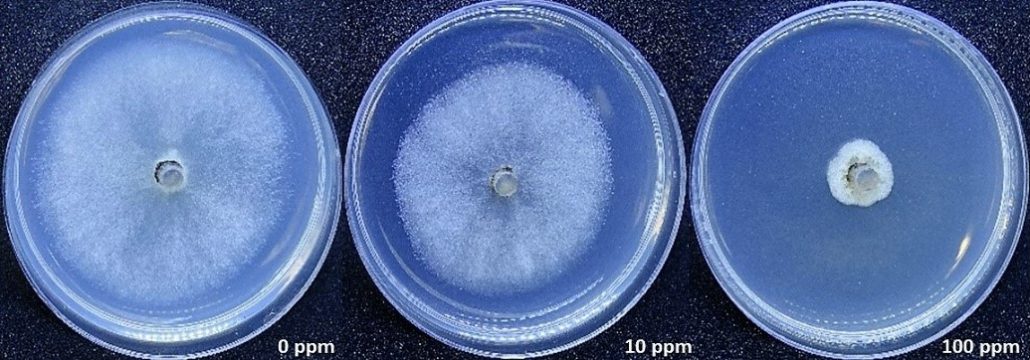

Fallece el asesor Tienie du Preez
Con un poco de atraso, finalmente he encontrado un minuto para escribir algo acerca de nuestro amigo Tienie du Preez, recientemente fallecido a mediados de febrero, luego de una larga batalla con el cáncer. Lo hago porque se lo debo, yo y muchos agrónomos que le conocimos y tuvimos el privilegio de aprender de él.
Fallece el asesor Tienie du Preez Leer más »